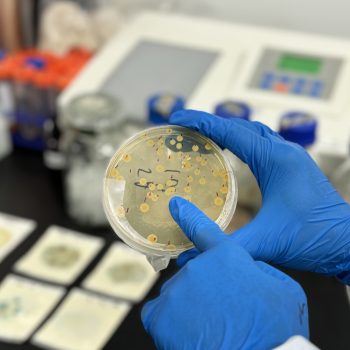

NATUREAL
What is Natureal?

Natureal is a 100% plant-based antimicrobial solution designed to protect your pets from harmful bacteria, viruses, fungi, and other toxic agents.
Powered by Singapore’s pioneering sustainability technology—ViKang™, Natureal offers a safe and eco-friendly way to keep your pet healthy and protected.
What is Antimicrobial?
Antimicrobials are substances that eliminate and inhibit the growth of harmful germs such as bacteria, fungi, and viruses.
How do Natureal work?
Natureal embeds the power of ViKang, an antimicrobial material derived from upcycled food ingredients. This technology not only eliminates bacteria, viruses, and fungi but also promotes wound healing, providing your pet with long-lasting protection.
How does Natureal benefits my pets?
Natureal embeds the power of ViKang™, an antimicrobial material derived from upcycled food ingredients.
This technology not only eliminates bacteria, viruses, and fungi but also promotes wound healing,
providing your pet with long-lasting protection.

How do Natureal benefits my pets?
Natureal offers a range of benefits for your pets:
- 99.9% Antimicrobial Protection (EN1276 Test Certified)
- 100% natural and safe, made entirely from upcycled food ingredients and free from chemicals and alcohol.
- Naturally eliminates bacteria, viruses, and fungi effectively.
- Providing 48 hours of continuous protection, preventing microbial buildup.
Is Natureal safe for pets?
Yes, Natureal is safe for both pets and humans!
The key ingredients of Natureal – ViKang™ come with a range of prestigious certifications, including Intertek’s 99.9%. It’s 100% human food-grade, contains natural antimicrobials, making it free from chemicals and alcohol. SGS REACH Test report is available.![]()
What Product can you expect from Natureal?
While we are in the process of finalizing our upcoming product offerings, Natureal is committed to delivering a range of high-quality pet hygiene solutions. Our current portfolio includes products incorporating the innovative ViKang technology, providing exceptional antibacterial properties, such as the Odour Eliminator & Sanitising Spray, among others.


